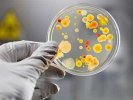
В поселке Новоуткинск ситуация полностью стабилизировалась

В поселке Новоуткинск, где произошло 11 случаев заболевания детей острой кишечной инфекцией, ситуация полностью нормализовалась. Новых случаев заболеваний не выявлено.
Эту информацию подтвердили сегодня на внеочередном заседании санитарно-противоэпидемической комиссии, которое прошло в администрации городского округа Первоуральск под председательством Елены Рожковой, заместителя главы администрации по управлению социальной сферой.
Представители здравоохранения, полиции, прокуратуры, водоканала, управления образования, контролирующих органов, руководитель ООО «Компания Таурас» и начальник СТУ отчитывались о принятых мерах и вновь анализировали возможные причины заболевания.
С 23 мая ситуация с заболеваемостью не изменилась: все так же зарегистрировано 11 случаев кишечной инфекции, новых заболевших нет. По состоянию на 27 мая лабораторно подтвержден диагноз дизентерия у одного ребенка из госпитализированных в медицинские учреждения, 6 - детей получают лечение в амбулаторных условиях.
Выполнены все мероприятия, направленные на предупреждение и распространения заболеваний. Забор бактериологических анализов произведен у всех сотрудников детского дошкольного учреждения и всех лиц, контактировавших с заболевшими детьми. Организовано медицинское наблюдение заболевших детей и контактных лиц. Был проведен стопроцентный осмотр ребят, посещающих детский сад. Всего обследовано 160 детей.
Проводится санитарно-просветительская работа, направленная на гигиеническое обучение населения, также раздаются памятки брошюрки по профилактике кишечных заболеваний. Лабораторные исследования в круглосуточном режиме проводили медицинские учреждения Первоуральска и лаборатории управления Роспотребнадзора.
Питьевая вода, подаваемая населению, тщательно дезинфицируется. Производится эффективная очистка и мероприятия по обеззараживанию объектов и систем питьевого водоснабжения детского сада и школы в поселке.
Обеспечен ежедневный лабораторный контроль воды, подаваемой населению во всех источниках и системах водоснабжения поселка Новоуткинск.
Более того, первоуральский МУП «Водоканал» сегодня заканчивает работу по созданию отдельной системы водоснабжения детского сада №30. В водяную сеть устанавливается заглушка. Система снабжения детского сада водопроводной водой будет изолирована от общепоселковой и тщательно промыта.
Состояние всех госпитализированных детей стабильное. Они получают все необходимое лечение в соответствии с установленными медицинскими стандартами. Дети, родители которых отказались от их госпитализации, получают необходимое лечение на дому.
Начальник территориального отдела управления Роспотребнадзора по Свердловской области в городе Первоуральск, Шалинском, Нижнесергинском районах и городе Ревда Сергей Бусырев сообщил, что вода в системе водоснабжения поселка Новоуткинск сейчас соответствует санитарным нормам и не могла стать источником заболевания.
По мнению Сергея Александровича, болезнь распространилась контактным путем. Начальник территориального отдела Роспотребнадзора считает, что кто-то во время апрельской вспышки острой кишечной инфекции в Новоуткинске не стал обращаться к врачам, перенес болезнь на ногах и стал распространителем для второй волны заболевших детей. Все участники сегодняшнего внеочередного заседания санитарно-противоэпидемической комиссии сошлись во мнении, что ситуация в Новоуткинске полностью стабилизировалась.
По решению заместителя главы администрации городского округа Первоуральск Елены Рожковой, санитарно-противоэпидемическая комиссия с сегодняшнего дня начинает работать в штатном режиме, отменена процедура обязательного уведомления единой диспетчерской службы о ситуации с заболеваемостью острой кишечной инфекцией. До этого подобное уведомление производилось каждые четыре часа.
@
www.pervo.ru